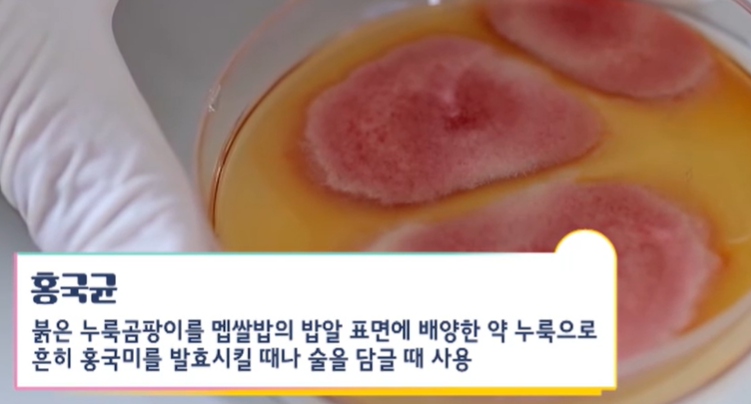
홍국균

티스토리 뷰
요즘 구기자를 발효한 '홍국 발효 구기자'가 상당한 인기를 끌고 있는데, 구기자란 무엇인지, 효능, 먹는 법, 섭취 시 주의사항에 대해 한번에 정리해 드릴 테니 도움 되시기 바랍니다.

목차
1. 구기자란?



구기자는 구기자나무의 열매로 붉은색을 띠며 쭈글 한 잣 모양처럼 생겼습니다. 구기자는 한국, 중국, 일본에서 모두 그 유례를 찾아볼 수 있는데 그만큼 약효가 다양하고 효능이 뛰어나다고 볼 수 있습니다.
먼저 우리나라에서는 아주 오랜 시간 동안 소갈(물을 많이 마시고 음식을 많이 먹으나, 몸은 여위고 오줌량이 많아지는 병증)이나 이뇨, 해열, 기침을 그치게 하는 등의 약재로 사용을 해왔습니다.

동의보감에 의하면 구기자가 정기를 보익하고 오래 복용하면 몸이 가벼워지면서 늙지 않고 더위와 추위를 견디는 힘이 강해지고 장수한다고 기록되어 있습니다.


특히 전라남도 진도는 토질이 좋고 일조량이 풍부하기 때문에 농산물의 품질이 워낙 좋기로 유명하기 때문에 진도산 구기자 열매가 아주 실하고 단맛이 강하다는 특징이 있습니다.

중국에서는 구기자를 장수의 명약으로 여겨서 불로장생을 꿈꿨던 중국의 진시황도 구기자를 즐겨 먹었다는 얘기가 있습니다.
진시황이 신하들에게 불로장생의 묘약을 찾아오라고 한 뒤에 세 가지 처방을 받았는데, 이 세 가지 처방 모두에 구기자가 포함되어 있어 불로초라고도 불립니다.

중국 의학서인 신농본초경에는 약효에 따라서 약재를 상약, 중약, 하약으로 나누고 있는데 구기자의 경우 부작용과 독성이 없는 상약으로서 오래 복용하면 근골을 강하게 하고 몸을 가볍게 하면서 늙지 않는다고 기록되어 있습니다.

본초강목에 보면 구기자가 독성이 없고 해열하면서 염증과 갈증을 수발하는 당뇨병이나 신경이 마비되는 질병 치료에 좋고 시력이 좋아지기 때문에 꺼져가는 등불에 기름을 붓는 것과 같다고 쓰여 있습니다.
2. 구기자 효능
1) 구기자 효능 : 동맥경화, 고혈압 관리

동양에서는 3대 명약이라는 별칭까지 갖게 된 구기자에는 카로티노이드, 베타인, 플라보노이드, 제아잔틴 등 항산화 성분이 풍부한데 이런 성분들은 혈관벽을 튼튼하게 하고, 동맥경화와 고혈압 관리에 도움을 줍니다.

2) 구기자 효능 : 중성지방 관리
그리고 혈관에 콜레스테롤과 중성지방이 과도한 고지혈증 환자들의 경우, 혈관을 깨끗하게 만들어야 요즘 같은 날씨에 혈압이 급격하게 상승하는 걸 막을 수 있는데요. 이때 구기자가 혈관 관리에도 도움 줄 수 있습니다.

실제 혈중 콜레스테롤이 높은 쥐에게 구기자 추출물을 투여했더니, 총 콜레스테롤과 중성지방 수치가 감소했다는 연구 결과가 있었습니다.
같은 실험에서 동맥경화증 발병 위험을 나타내는 동맥 경화 지수 또한 유의미적으로 감소했고, 심혈관 위험 지수도 유의하게 감소했음이 확인되었습니다.
3) 구기자 효능 : 치매 예방

혈관이 깨끗해지면 치매 예방에도 도움을 줄 수 있습니다. 뇌의 경우 혈액 순환이 잘 안 되면 신경세포와 뇌세포가 서서히 죽으면서 기억력 저하가 생기고 치매로까지 이어질 수 있습니다.

반대로 뇌혈관이 깨끗해지면 알츠하이머 치매를 유발하는 도파민 물질이 뇌에 침착하는 것을 예방할 수 있습니다.

실제로 치매가 있는 쥐에게 구기자 추출물을 투여한 결과, 치매 원인 물질인 아밀로이드 베타 플라크의 침착이 개선이 되었고, 기억력을 담당하는 해마 신경세포 활성 물질이 개선되어 손상된 뇌신경세포가 활성화되었다는 연구 결과도 있었습니다.
4) 구기자 효능 : 항당뇨 효과


피가 끈적끈적해지면 혈전도 더 잘 생기기 때문에 당뇨 환자 등은 혈당 관리를 철저하게 해야 합니다. 이때 구기자가 도움이 됩니다.

실제 당뇨를 유발한 쥐에게 구기자 추출물을 약 7일간 투여를 하자 혈당이 대조군에 비해서 뚜렷하게 감소하는 결과를 볼 수 있었습니다.

또 다른 연구에서는 구기자 추출물이 고혈당 쥐의 지방 축적을 억제하고 인슐린 저항성을 개선했다고 합니다.
5) 구기자 효능 : 콜레스테롤 개선
한 실험에서 물 위에 뜬 기름을 혈액 속의 과도한 ldl 콜레스테롤과 중성지방이라고 가정하고 각각의 비커에 혈관을 깨끗하게 만드는 데 도움을 준다고 알려진 녹차가루, 양파가루, 발효 구기자 분말을 넣어 봤습니다.


시간이 지날수록 각각의 비커의 눈에 띄는 변화가 생기는데 구기자는 바로 기름을 뭉텅이로 흡수하는 것을 볼 수 있습니다. 즉, 이런 식으로 발효 구기자가 혈관 속 나쁜 콜레스테롤과 중성지방을 흡착해서 몸 밖으로 배출하는 데 도움을 준다고 볼 수 있습니다.

이는 홍국균 발효 과정에서 생성되는 성분인 모나콜린 k 때문입니다. 모나콜린 K는 혈관 속 나쁜 콜레스테롤과 중성지방을 배출하는 데 도움을 주는데 실제로 고지혈증 환자들에게 홍국쌀 보충제를 8주간 섭취하게 한 결과 총콜레스테롤은 22.7% ldl 콜레스테롤은 약 31%, 중성지방은 약 34%나 감소했다는 연구 결과가 있었습니다.

이러한 효과 때문에 우리나라 식약처에서도 홍국과 홍국쌀을 콜레스테롤 수치 개선을 위한 고시형 원료로 인증하기도 했습니다.

빨간 구기자와 빨간 홍국균이 만나면 증가하는 핵심 성분이 있는데 바로 베타인입니다. 베타인은 지방에 잘 달라붙는 성질이 있어 혈액 속에 나쁜 콜레스테롤과 중성지방 등을 흡착을 해서 배출하고 이로 인해 혈당과 혈압을 조절하는 데 도움을 줄 수가 있습니다.

실제로 구기자를 홍국균으로 발효하면 베타인 성분이 일반 구기자 대비 무려 151%나 높아진다고 합니다.
3. 구기자 똑똑하게 먹는 법
구기자를 먹을 때에는 일반 구기자보다 발효한 진도산 구기자 분말이 구기자 효능을 얻는데 더 도움 될 수 있습니다. 진도산 구기자 분말이 일반 구기자보다 좀 더 진한 붉은색을 띠는 이유는 두 번의 발효를 거쳤기 때문인데요.


보통 구기자의 주요 성분은 고분자 다당체 형태이기 때문에 체내에 들어와도 흡수가 충분히 되지 않고 배출되는 경우가 많습니다. 그런데 발효 과정을 거쳐 고분자를 저분자로 만들면 체내 흡수율이 높아질 수 있습니다.
특히 진도산 구기자 분말의 경우 구기자를 유산균으로 발효시킨 다음 홍국균으로 또 한 번 발효를 시켜 만든 것입니다. 홍국균은 붉은 누룩곰팡이를 맵쌀밥의 밥알 표면에 배양한 약 누룩으로 흔히 홍국미를 발효시킬 때나 술을 담글 때 사용합니다.

홍국도 구기자처럼 아주 오랜 시간 동안 약재로 사용되어 왔습니다. 약 2200년 전에 한나라 황제 유방이 홍국을 황실 음식으로 채택해서 혈액을 개선하는 약재로 사용했다는 기록이 있습니다.


또한 중국 남부와 대만에서는 건강과 장수를 위해서 홍국으로 술을 빚어서 마셨다고 합니다. 중국 의학서인 본초강목에는 홍국이 혈액순환을 촉진하고 소화 기능을 튼튼하게 한다고 기록되어 있을 만큼 중국 사람들은 오랜 시간 홍국을 건강에 유익한 식품, 약재로 여기고 사용해 왔습니다.

구기자를 먹을 때에는 잎이랑 열매를 함께 섭취하면 혈관 건강을 더 건강하게 유지하는 데 도움을 받을 수 있습니다. 구기자의 핵심 성분인 베타인은 열매뿐만 아니라 잎에도 풍부하기 때문입니다.

참고로 구기자 잎의 베타인 함량은 평균 1.29mg 정도로 열매에는 0.85mg 정도의 베타인이 함유되어 있습니다. 구기자는 분말 가루를 차로 우려 뜨겁게 먹어도 좋고 차게 먹어도 괜찮습니다. 또 밥이나 샐러드에 드레싱처럼 뿌려 먹어도 거부감이 없습니다.
4. 구기자 섭취 시 주의사항


홍국균으로 발효한 구기자 분말은 하루 5g 정도만 드시는 게 적당합니다. 발효 구기자 분말을 너무 많이 과다하게 섭취하면 복통이나 설사를 유발할 수 있으니 주의가 필요합니다.

또한 임산부나 어린이, 기저질환자는 전문의와 상의 후 발효 구기자 분말을 섭취를 결정하는 게 좋겠습니다.
이상 구기자에 대해 알아보았는데, 혈관 관리에 도움 되는 오메가 3 효능과 고르는 법에 대해서도 알아보시고 도움 되시기 바랍니다.
'건강 정보' 카테고리의 다른 글
| 비오틴 효능, 함께 먹으면 좋은 콜라겐 영양제 추천 (0) | 2024.03.02 |
|---|---|
| 아누카 사과 분말 효능, Best 5가지 (0) | 2024.03.02 |
| 대마종자유 효능, BEST 6가지! (0) | 2024.02.29 |
| 맥주효모 효능 Best 10, 주의사항, 부작용, 먹는 방법 (0) | 2024.02.29 |
| 저분자 콜라겐 펩타이드 효능, 함께 섭취하면 좋은 성분 및 주의사항 (1) | 2024.02.28 |
